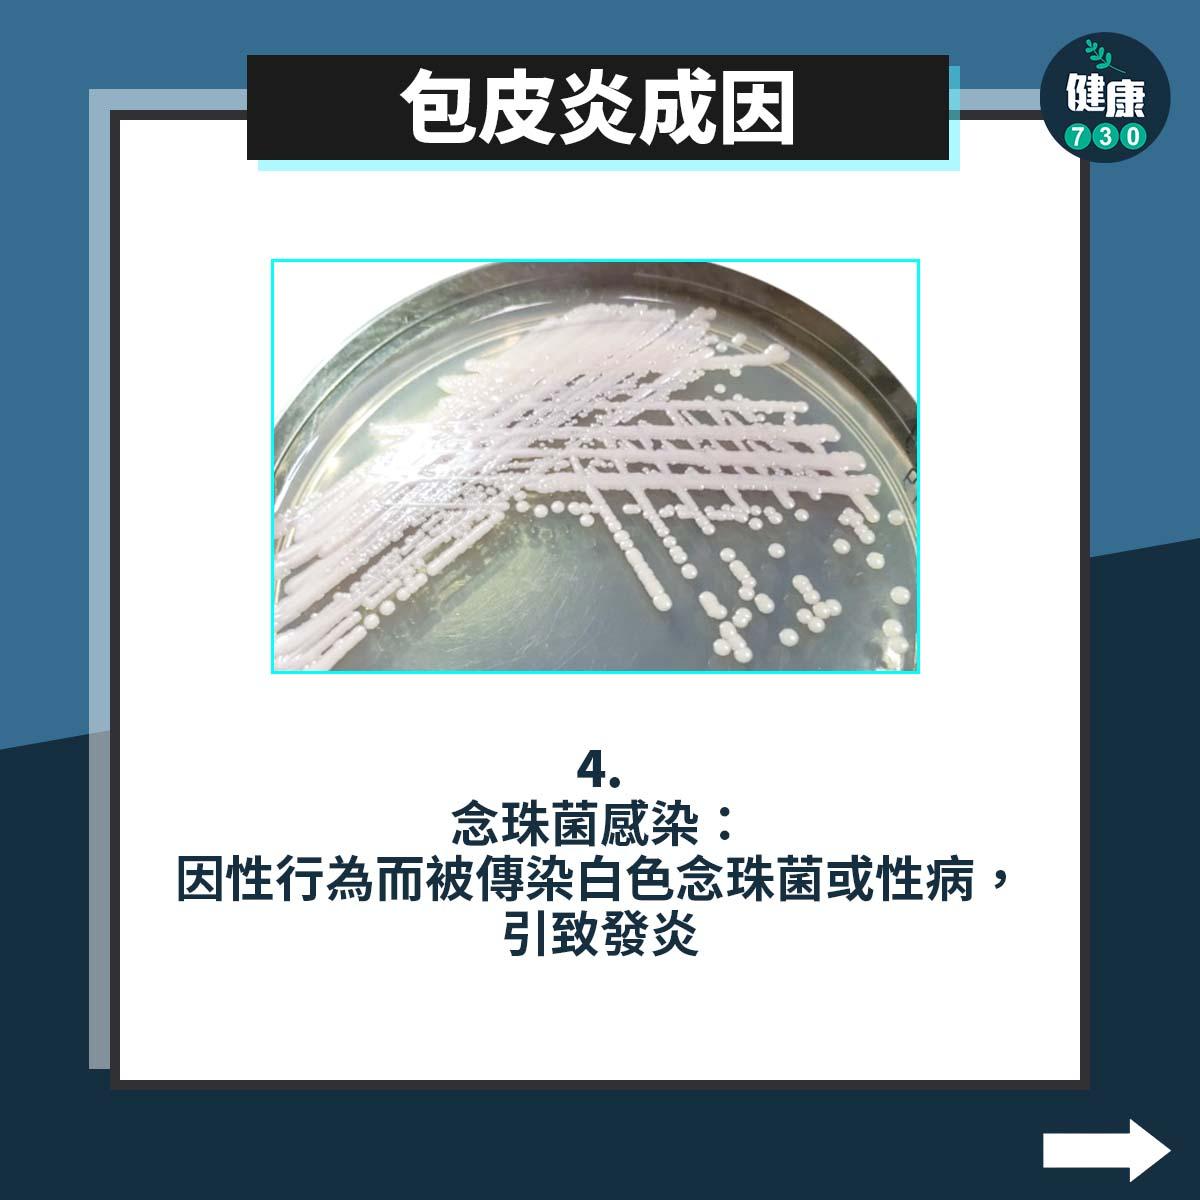
男性疾病|包皮炎成因包括包皮過長等原因(am730製圖)

包皮炎(Posthitis)是男人最痛的其中一種炎症。
包皮炎(英文︰posthitis)在香港是男性最常見的生殖器官疾病之一,不少包皮炎患者都非常緊張,擔心自己患上性病。其實患上包皮炎有不同原因,更與「龜頭炎」(英文︰balanitis )是不同的疾病。到底包皮炎有甚麼症狀?會自己好嗎?今次Bowtie團隊就整合了「包皮炎」的相關資訊,更附上中醫食療供大家參考。
包皮炎是甚麼?
包皮炎是指包皮呈現急性或慢性炎症,由於包皮内潮濕溫暖的環境,較容易引起細菌滋生,因此包皮炎相對地較常見於沒有割除包皮、包皮過長或患有包莖的男士。
▼引致包皮炎 6 大成因▼
▼急性包皮炎症狀▼
包皮炎治療方法
藥物治療
針對包皮炎的感染原因,可使用不同藥物治療,例如藥膏或口服藥物。
- 抗真菌藥膏:使用含有弱中強度的類固醇、抗生素及抗黴菌藥物的三合一藥膏,按照醫生指示將藥膏塗抹在包皮上。
- 抗生素:如果性傳播疾病是症狀的原因,醫生會使用抗生素治療感染,嚴重者會搭配口服藥物。
包皮切除手術
若病患是因為包皮過長而患上包皮炎,醫生可能會建議進行包皮切除手術,避免反覆感染與發炎。糖尿病患者在進行包皮切除手術之前,需要先控制好自己的血糖,否則手術後傷口會很容易感染。
中醫食療
中醫指出,在包皮炎的發病過程及恢復期,可配合飲食療法,除了禁食辛辣食物外,亦可根據病情選擇下列食療方法:
包皮炎多久會痊癒?
包皮炎的痊癒時間取決於病情的嚴重程度,一般難以以自身抵抗力痊癒。
如果只是輕微的包皮炎,患者可以嘗試仔細清洗患處,以低刺激性的沐浴露清潔陰莖和包皮並徹底抹乾,或有機會會自行痊癒;嚴重者則需要接受進一步的治療。
包皮炎改善方法
要改善包皮炎,可以由以下方向著手:
- 經常洗澡:每天清洗,及務必將包皮向後拉,以便清潔下方。
- 避免使用刺激性肥皂:盡量不要使用會刺激皮膚的強力肥皂或乳液。
- 保持乾燥:排尿後,擦乾包皮下的區域,以免尿液滯留在包皮下。
- 教導正確的衛生習慣:教導男孩從小培養適當的衛生習慣。
- 安全性行為,女伴患上陰道炎或念珠菌時,應避免性行為。
銀花、茅根煎煮代茶飲用可有效清熱解毒。
包皮炎常見問題
包皮炎是性病嗎?
雖然念珠菌及性病感染會引致包皮炎,但包皮炎本身並不是性病,也沒有傳染性。細菌感染才是引致包皮炎的常見成因,尤其是個人衛生欠佳,令包皮下積聚污垢,其潮濕溫熱的狀態增加細菌滋生,引致發炎。
因此,除了使用安全套預防性病外,亦要注意個人衛生,才能有效預防包皮炎。
包皮龜頭炎是甚麼?
包皮龜頭炎跟包皮炎類近,包皮炎的症狀集中在包皮上,包皮會紅腫、癢、刺痛或脫屑;但包皮龜頭炎患者會同時發生龜頭、包皮都發炎的情況,所以稱為「包皮龜頭炎」。
資料來源:
本文獲Bowtie 保泰人壽授權轉載
女伴患上陰道炎或念珠菌時,應避免性行為。